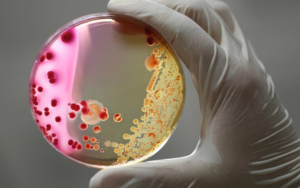
bacteria

Modules thanatopraxie
Les modules de thanatopraxie sont disponibles à la carte pour préparer au mieux votre concours théorique ou pour monter en compétences selon vos besoins.
Contactez Nous
Les modules de thanatopraxie sont disponibles à la carte pour préparer au mieux votre concours théorique ou pour monter en compétences selon vos besoins.
Contactez Nous

Durée : 2h à distance

Durée : 20h à distance

Durée : 35h à distance

Durée : 65h à distance

Durée : 25h à distance

Durée : 14h à distance

Durée : 10h à distance

Durée : 20h à distance

Durée : 20h à distance

Durée : 40h à distance

Durée : 18h à distance
La formation est ouverte à tout public majeur, demandeur d’emploi ou salarié.
Être reçu à l’examen théorique et classé en rang utile.
Pour s’inscrire à l’examen, une attestation de fin de formation théorique datant de moins de cinq ans doit être présentée.
Vaccination à jour (DTP et Hépatite B).
Nous répondons à toutes vos interrogations à l’adresse mail:
Ou contactez-nous en cliquant ci-dessus
Appelez-nous au 04 67 45 41 41 et si vous êtes :
Et « 98 » pour une formation Thanatopraxie